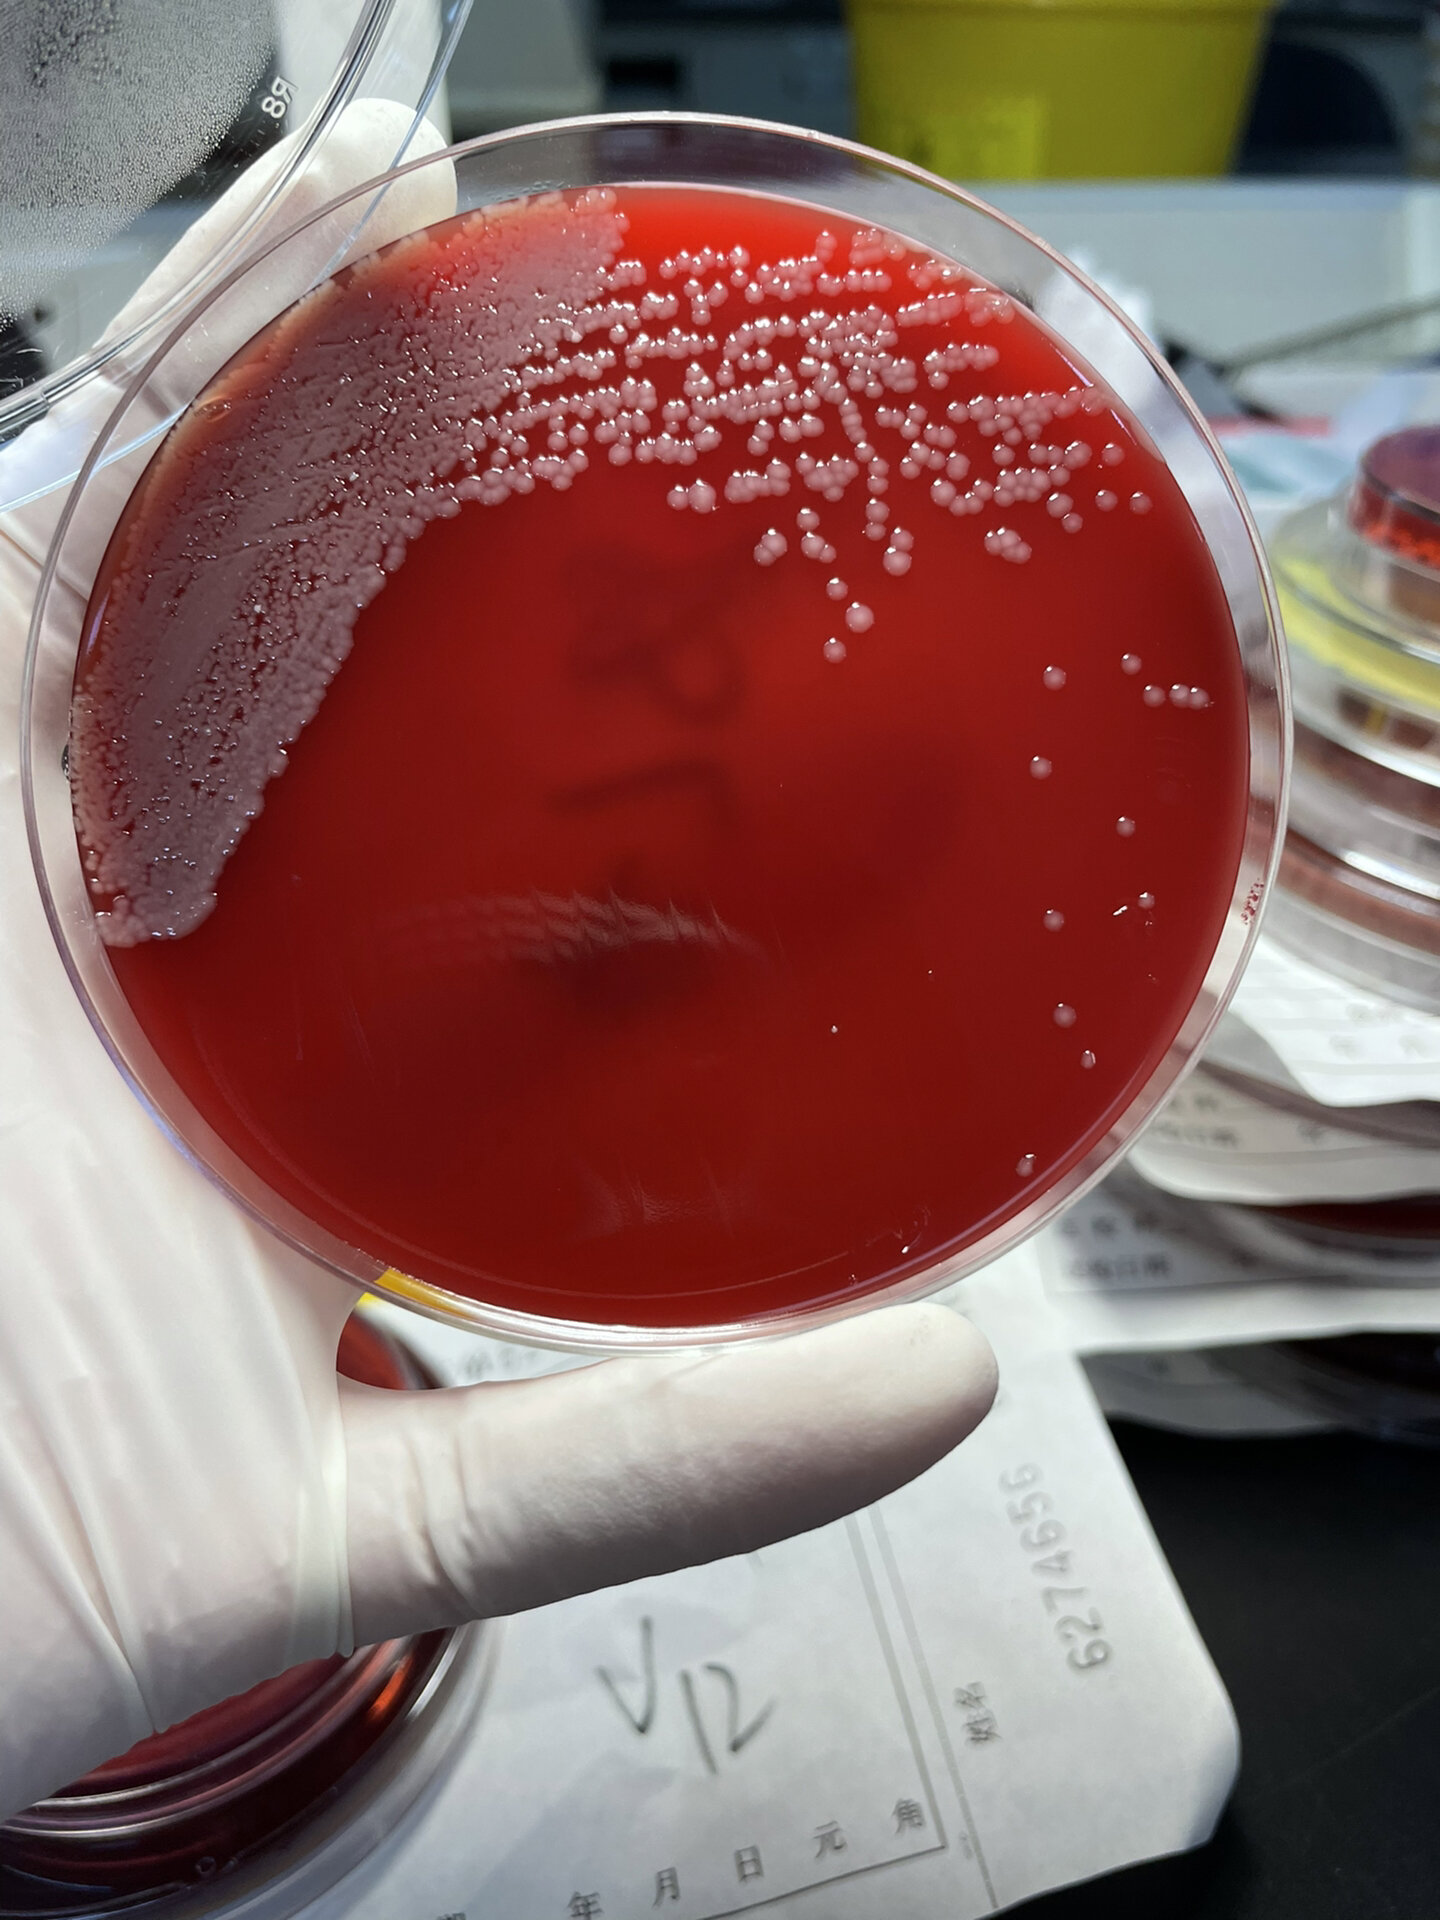
鲍曼不动杆菌 镜下革兰阴性杆菌
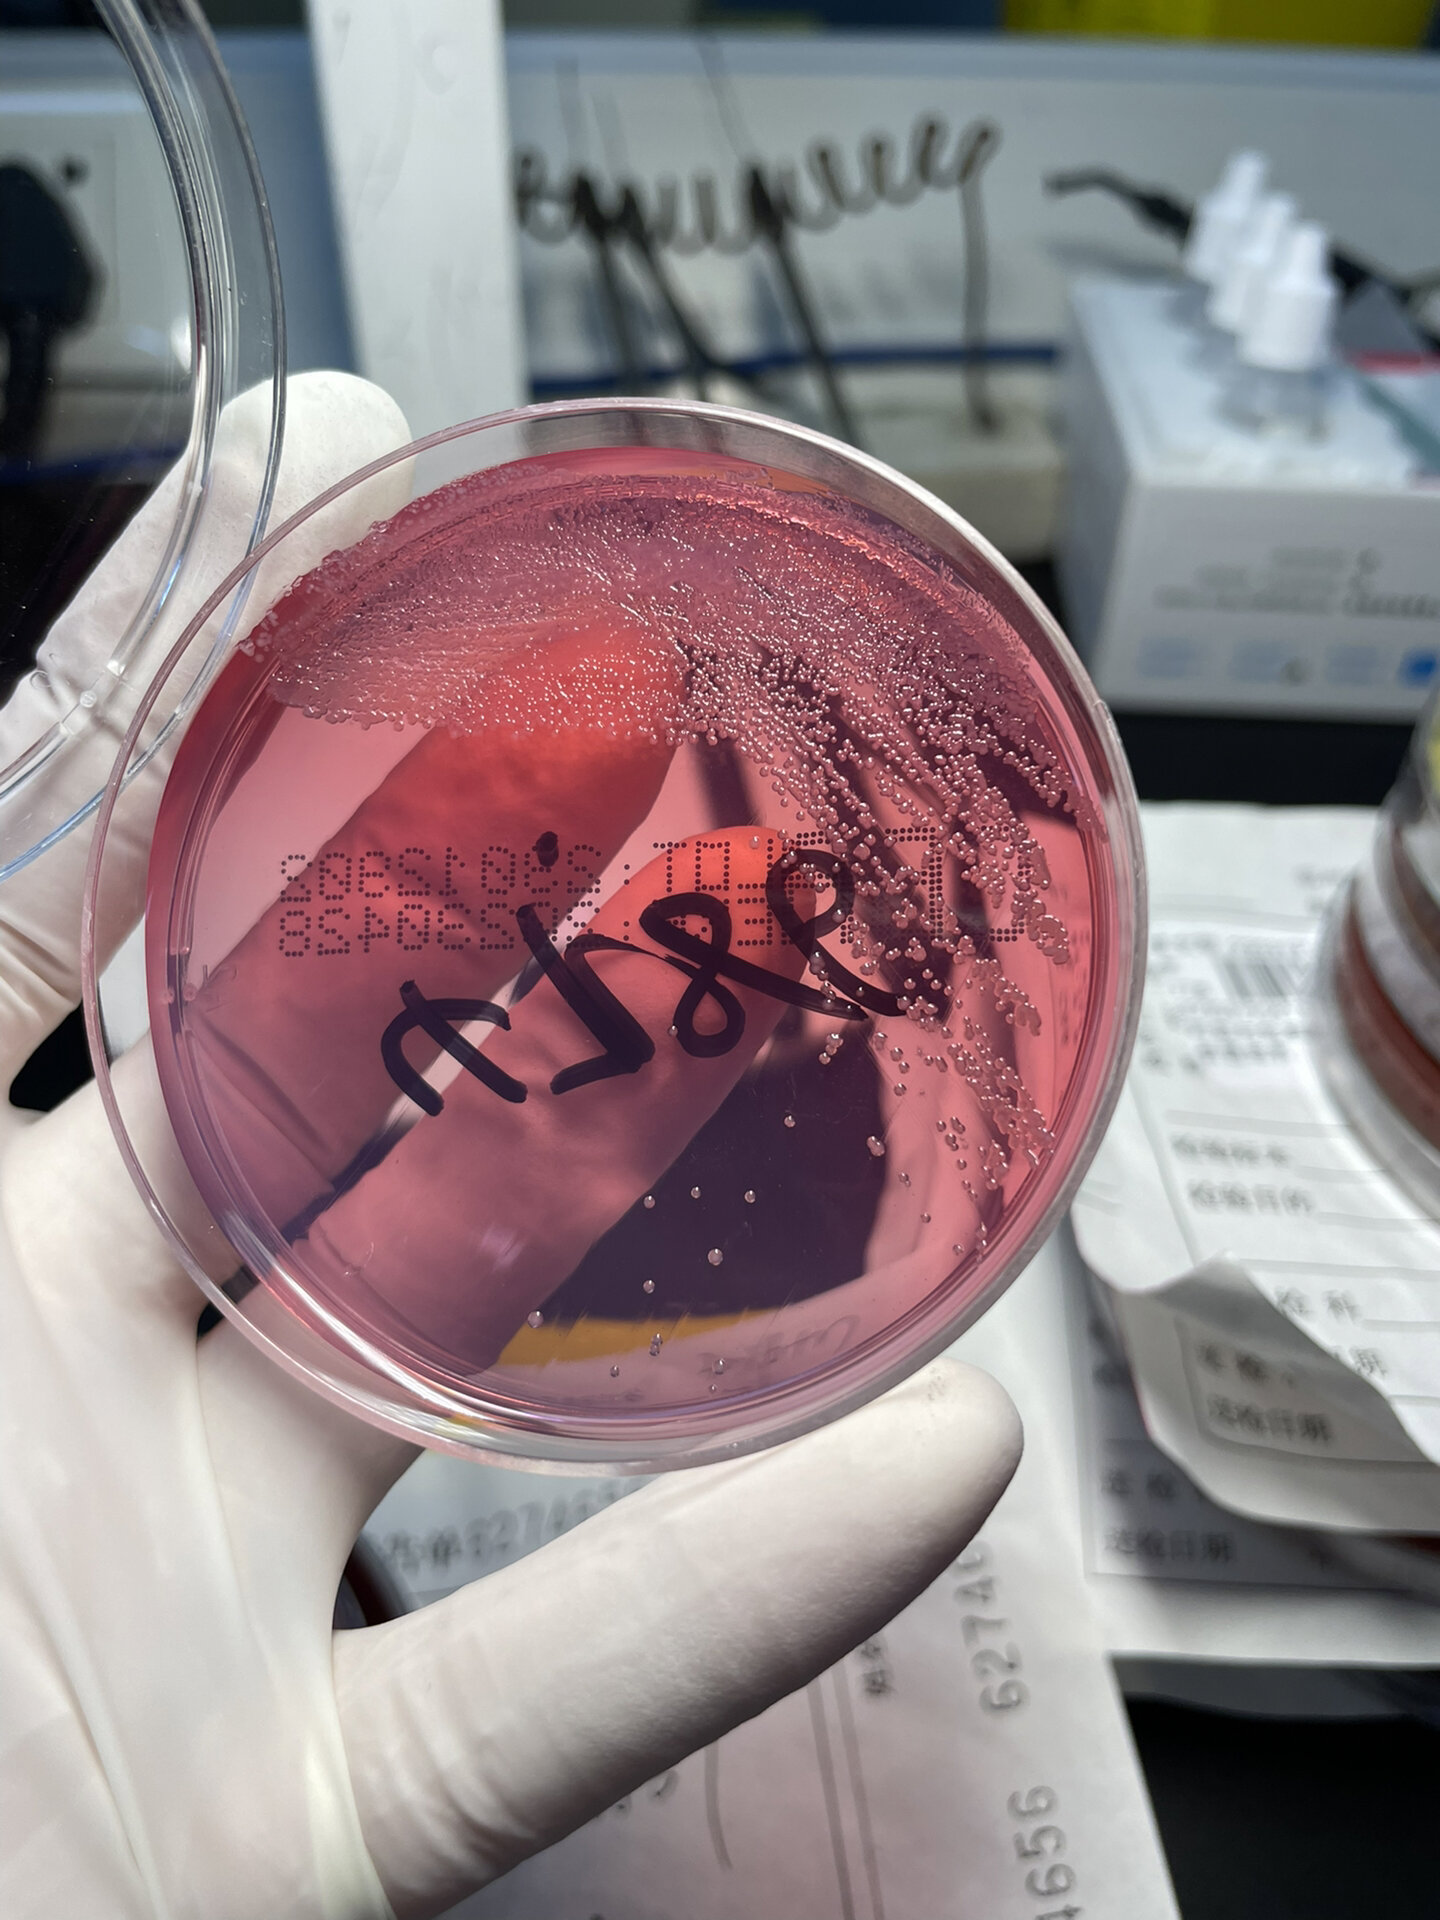
鲍曼不动杆菌 镜下革兰阴性杆菌
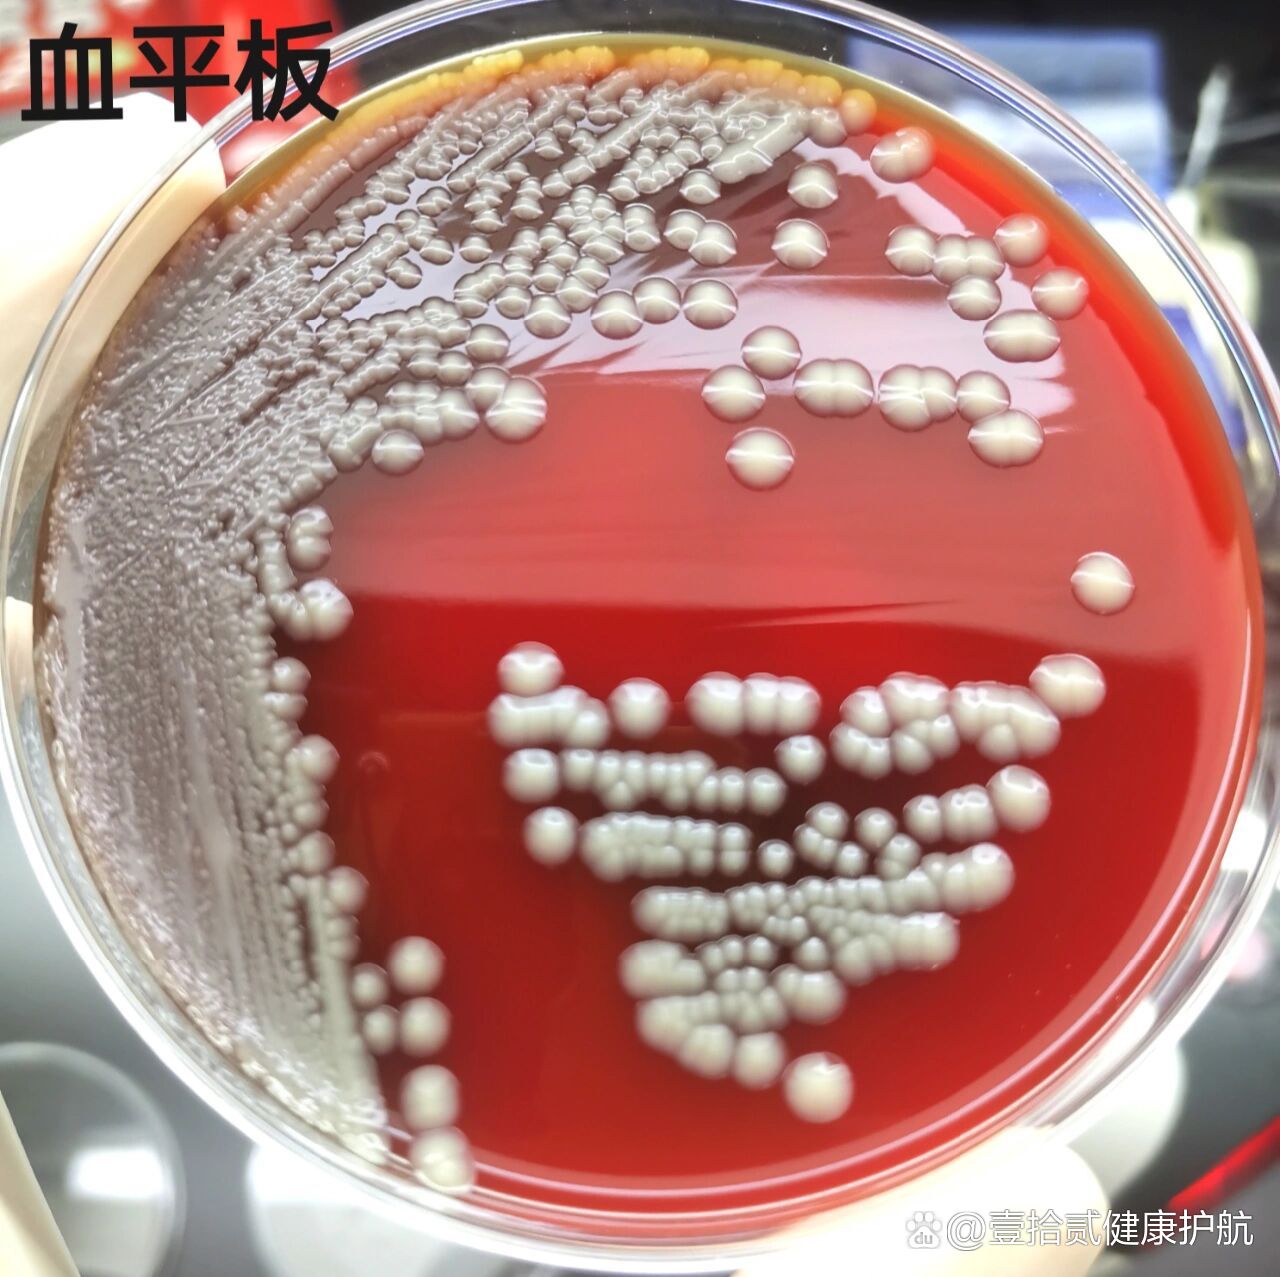
鲍曼不动杆菌
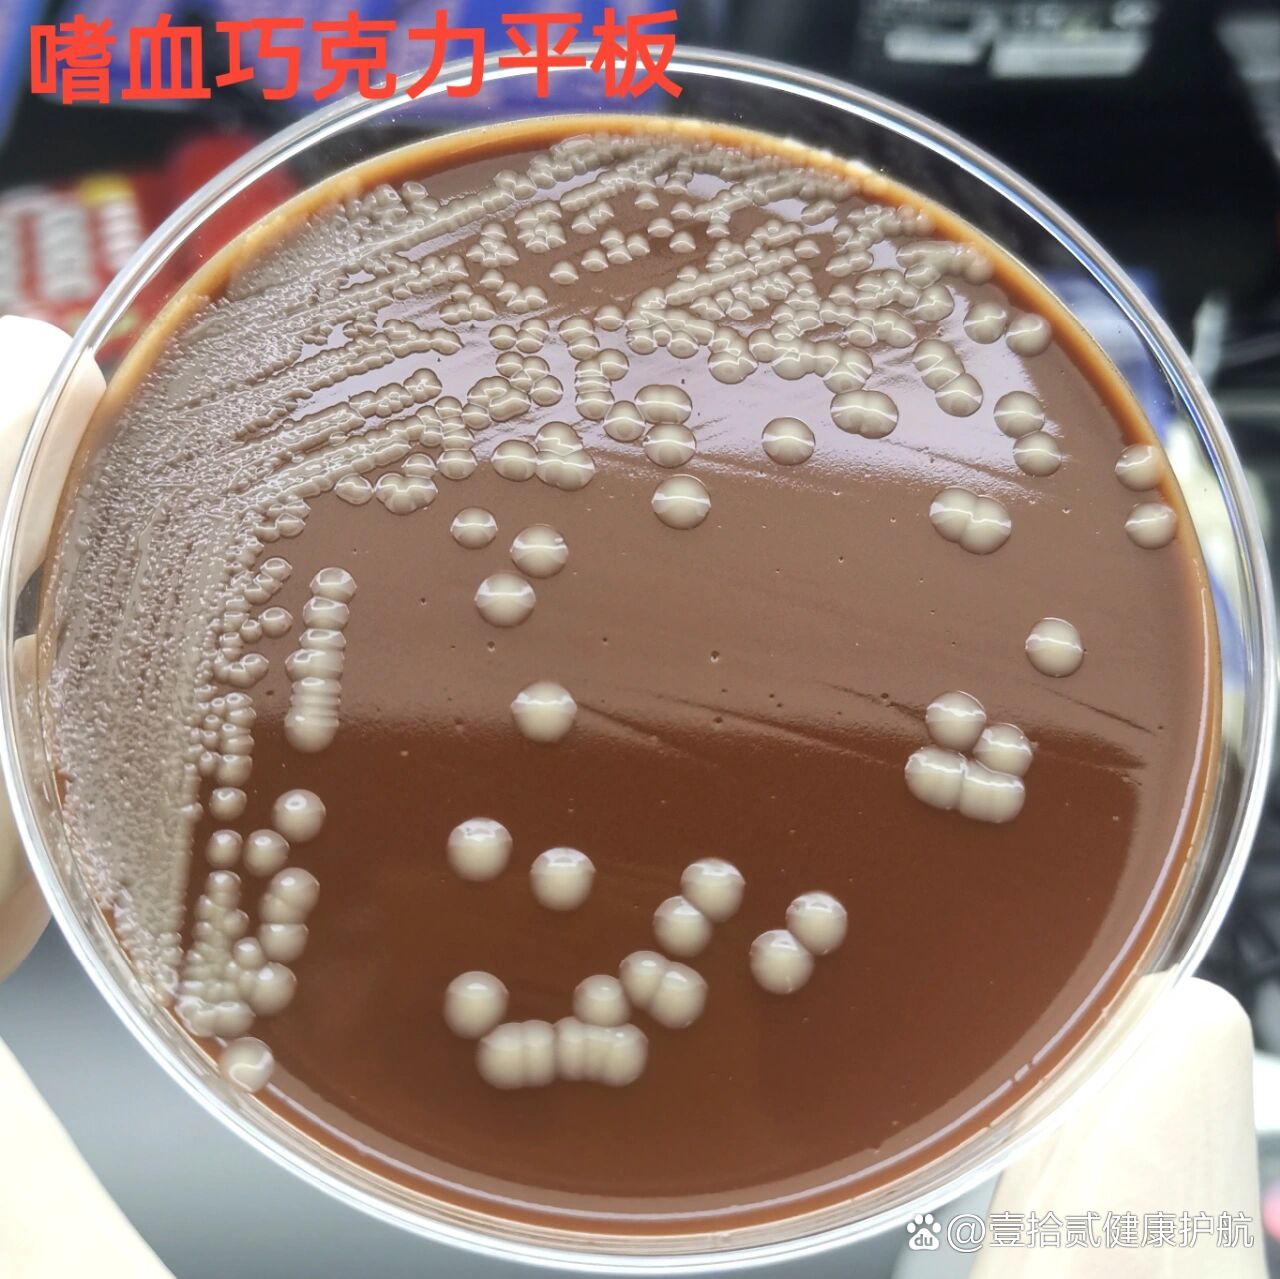
鲍曼不动杆菌
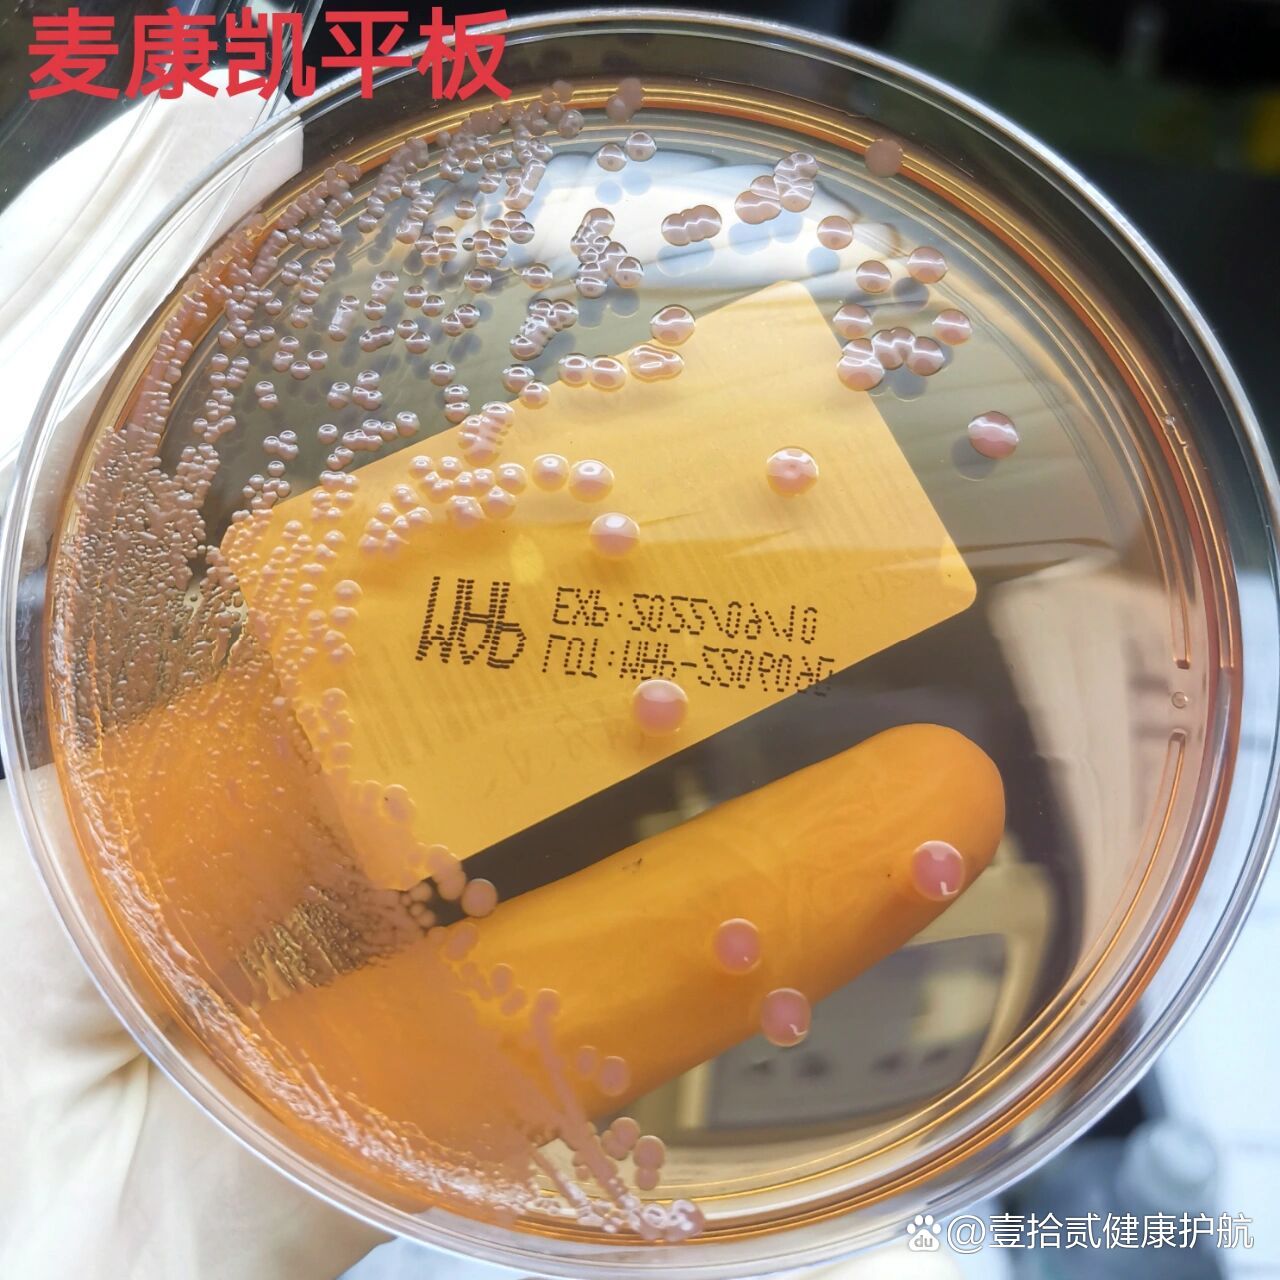
鲍曼不动杆菌
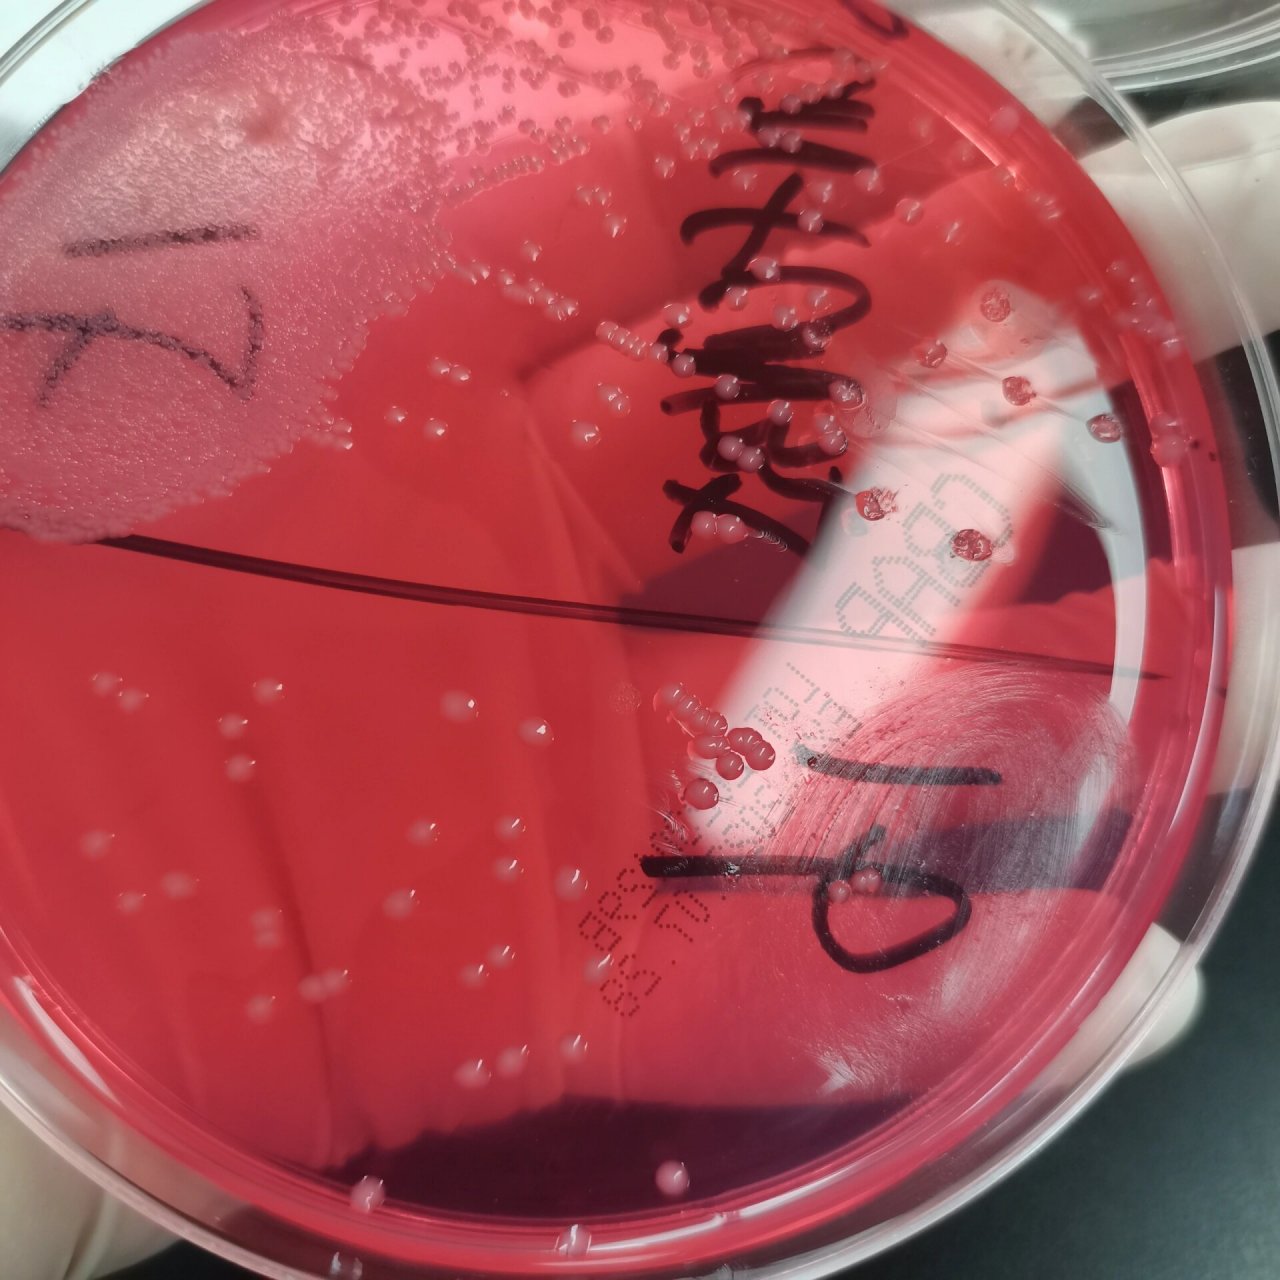
合格痰的标本长出大量的鲍曼不动杆菌菌!浅谈一下它的临床意义
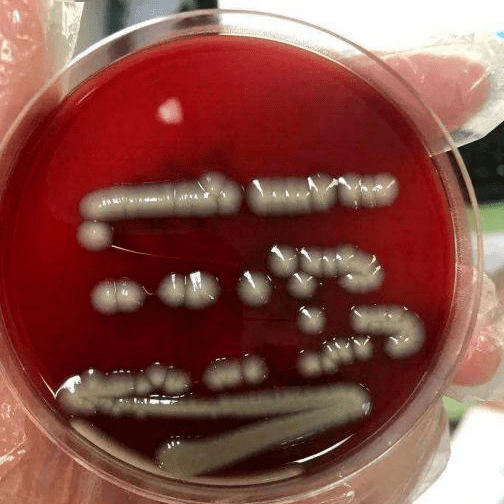
"刀枪不入"的危险细菌——鲍曼不动杆菌_培养基_消毒剂_能力

鲍曼不动杆菌

鲍曼不动杆菌 镜下革兰阴性杆菌
图片尺寸1440x1920
鲍曼不动杆菌
图片尺寸1920x1440
鲍曼不动杆菌
图片尺寸1920x1440
鲍曼不动杆菌 镜下革兰阴性杆菌
图片尺寸1440x1920
鲍曼不动杆菌
图片尺寸1280x1278
鲍曼不动杆菌
图片尺寸1280x1277
鲍曼不动杆菌
图片尺寸1280x1279
鲍曼不动杆菌
图片尺寸1280x1280
鲍曼不动杆菌
图片尺寸640x464
合格痰的标本长出大量的鲍曼不动杆菌菌!浅谈一下它的临床意义
图片尺寸1280x1280
"刀枪不入"的危险细菌——鲍曼不动杆菌_培养基_消毒剂_能力
图片尺寸338x338
"刀枪不入"的危险细菌——鲍曼不动杆菌_培养基_消毒剂_能力
图片尺寸504x504
一文认识鲍曼不动杆菌
图片尺寸400x306
鲍曼不动杆菌
图片尺寸660x356
鲍曼不动杆菌感染:了解它,战胜它!
图片尺寸1242x1660
鲍曼不动杆菌-伟业计量
图片尺寸417x417
鲍曼不动杆菌,是怎么引起的?
图片尺寸1600x1280
鲍曼不动杆菌(其他生物相关)_技点百科_技点网(其他生物相关)
图片尺寸1200x816
鲍曼不动杆菌
图片尺寸1080x1217
鲍曼不动杆菌的3d插图
图片尺寸1200x675